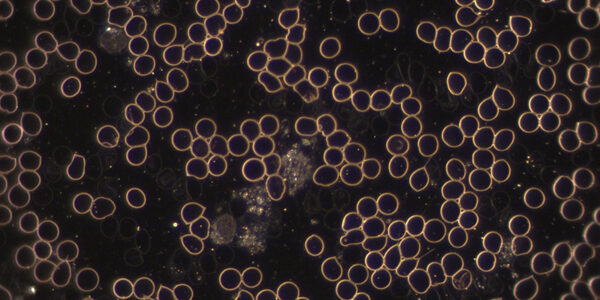
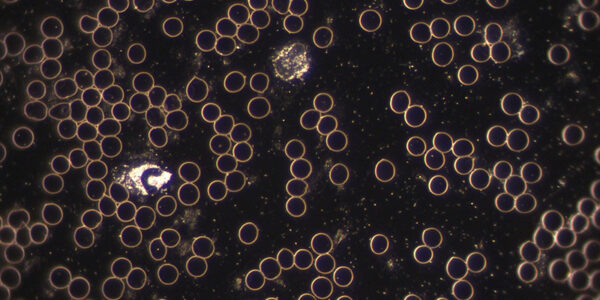

Die Dunkelfeld-Diagnostik ist eine innovative Methode, die tiefere Einblicke in den Zustand des Blutes und somit des gesamten Gesundheitsstatus eines Menschen bietet. Sie ermöglicht die Beobachtung spezifischer Phänomene, die auf verschiedene Gesundheitsproblematiken hinweisen können.
Ein besonders häufiges Phänomen sind die sogenannten Bärentatzen, bei denen die roten Blutkörperchen (Erythrozyten) eine tatzenähnliche Form annehmen. Dies deutet in der Regel auf Fettstoffwechselstörungen hin und kann ein Indiz für ungesunde Ernährungsgewohnheiten oder metabolische Probleme sein.
Ein weiteres bemerkenswertes Zeichen ist die Geldrollenbildung, die auf verschiedene Umweltbelastungen wie Schwermetalle oder Elektrosmog hinweisen kann. Hierbei kleben die Erythrozyten so zusammen, dass sie wie Geldrollen erscheinen, was auf eine Beeinträchtigung der Blutzirkulation und der Sauerstoffversorgung hindeutet.
Zusätzlich kann das gehäufte Vorkommen von eingetrockneten Überresten aus dem Stoffwechsel (Symplasten) auf einen unausgewogenen Säure-Basen-Haushalt oder bestimmte Stoffwechselstörungen hinweisen. Eine solche Dysbalance kann weitreichende Auswirkungen auf die Gesundheit haben und sollte unbedingt betrachtet werden.
Ein weiteres Zeichen, die sogenannten Filite, sind helle, nadelförmige Gebilde im Plasma und treten häufig bei Durchblutungsstörungen und Stauungen im Körper auf. Diese Indikatoren können dabei helfen, gezielte therapeutische Maßnahmen zu ergreifen, um die Blutzirkulation zu verbessern und die Gesundheit zu fördern.
Ermutigende Ergebnisse zeigen erste Dunkelfeld-Analysen, bei denen nach nur 20 Minuten der Einnahme von Lichtwasser eine signifikante Verbesserung der Blutqualität beobachtet wurde. Insbesondere die Geldrollen lösen sich auf, was auf die Aktivierung des Immunsystems und der Entgiftungsmechanismen im Körper hinweist.
Insgesamt bietet die Dunkelfeld-Diagnostik wertvolle Einsichten, die dabei helfen können, die Gesundheit zu optimieren und präventive Maßnahmen zu ergreifen. Sie ist ein wertvolles Werkzeug im Bereich der alternativen Medizin und der Gesundheitsvorsorge.
In seinem höchstorganisierten Zustand bildet Wasser ein flüssigkristallines Netz, das hexagonale Strukturen aufweist, ähnlich dem biologischen Gewebe im menschlichen Körper. Laut Prof. Gerald Pollack kann Wasser in den bindegewebigen Strukturen des Körpers schnell zwischen flüssig und gelartig wechseln, eine Fähigkeit, die als thixotrop bezeichnet wird. Hexagonales Wasser, das einen hohen pH-Wert über 12 aufweist, ist essenziell für den Stoffwechsel, die Entgiftung und die Zellkommunikation. Ein neues Verfahren stabilisiert dieses Wasser in Gelform, wodurch es tief in Zellen eindringen, Schwermetalle binden und antioxidative Eigenschaften entfalten kann. Es lädt den Körper wie eine Batterie mit elektrischer Energie auf und fördert somit die Gesundheit.
Der 4. Aggregatzustand von Wasser: Die Basis biologischen LebensEin Forscherteam an der Universität Washington, unter der Leitung des weltbekannten Wasserforschers Prof. Gerald Pollack, hat möglicherweise das Geheimnis des Wassers gelüftet. Sie entdeckten einen vierten Aggregatzustand des Wassers, der neben den bekannten Zuständen fest, flüssig und gasförmig existiert. Dieser neu entdeckte Zustand, den die Wissenschaftler „EZ-Wasser“ (Exclusion Zone-Wasser) nennen, zeichnet sich durch eine hexagonale (sechseckige) Kristallgitterstruktur aus.
Die Entdeckung dieses vierten Zustands zeigt einige erstaunliche Eigenschaften, die unser Verständnis von Wasser revolutionieren könnten. EZ-Wasser bildet sich in der Nähe von hydrophilen (wasserliebenden) Flächen, die überall in unserem Körper vorkommen. In diesen Bereichen teilt sich das Wasser in zwei Schichten, wobei eine Schicht sich in dieses spezielle, hexagonal geordnete Wasser verwandelt, das sich von herkömmlichem H2O deutlich unterscheidet.
Dieses „Ausschlusszonen-Wasser“ hat die bemerkenswerte Fähigkeit, sich selbst zu reinigen. Es verdrängt alle gelösten Stoffe aus seiner Zone, wodurch eine Schicht reinen Wassers entsteht. Diese Zone ist etwa einen Viertel Millimeter dick und bildet sich überall dort, wo Wasser auf hydrophile Oberflächen trifft. Die Entdeckung dieses hoch energetischen, hexagonalen Wassers bestätigt, dass es sich nicht um eine „esoterische Spinnerei „handelt, sondern um eine nachweisbare Realität, die unser Verständnis von biologischem Leben grundlegend beeinflussen könnte.

Beate, Proband weiblich 67 Jahre, agile Rentnerin
Blutbild vor der Therapie.
Blutbild nach 20 Minuten
---

Ernst , Proband männlich 70 Jahre, agiler Rentner
Blutbild vor der Therapie

Blutbild nach 20 Minuten
---

Josef, Proband männlich 62 Jahre, Geschäftsführer
Blutbild vor der Therapie
Blutbild nach 20 Minuten
---
Blutbild vor der Therapie. Geldrolleneffekt, Bärentatzen, verklumptes Blut, unkontrollierte Verteilung der Blutkörperchen.
Blutbild nach 20 Minuten nach der Einnahme von einem Pump Sprüher AURORA Vitra Lichtwasser Gel in einen viertel Liter Wasser. Das Blutbild zeigt eine deutliche Verbesserung. Die Geldrolle lösen sich auf, das Immunsystem startet, natürliche Verteilung der Blutplättchen.